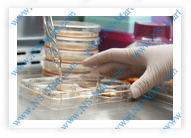

Eco-Ultrafiltrates are extracts from stem cells that are used for the regeneration of inefficient or defective organic structures, disrupted regulating systems and for the improvement of bodily functions due to deterioration by diseases and aging. They supply the biological building blocks (on a molecular level) to help optimize and maximize your body's metabolic processes. Eco-Ultrafiltrates serve primarily for substitution and secondarily for triggering repair and regeneration of cellular health.
The therapeutic challenge of a patient about 40 years ago inspired the development of the Eco-Ultrafiltrates of fetal and juvenile organs. An 8 year-old girl sustained deep burns to the upper right side of her body when a petroleum stove exploded. A disfiguring hypertrophic scar developed on her neck and face.
The attempt to eliminate the half-inch-thick hypertrophic scar with contracture by applying specially prepared cell extracts from fetal skin was so successful, it demanded greater research and development.

After such success, the cell extracts from skin were applied to other patients with severe deep burns that were untreatable by any other means. In field tests in Switzerland and Germany, the therapeutic range of application for various Ultrafiltrates was tested and a wide variety of benefits was discovered.
 The Technology Behind EUF (Eco-Ultrafiltrates)
The Technology Behind EUF (Eco-Ultrafiltrates)
After the absorption of fetal Eco-Ultrafiltrates through the intact skin was proven possible, their epithelialising effect was demonstrated by an impressive histological study by F. Leyh from 1981 to 1983. If skin permitted the absorption of Eco-Ultrafiltrates, it was probable that the mucosa would also permit transport of Ultrafiltrates to any and all organs and tissues even better than the skin. An oral method of administration of Eco-Ultrafiltrates was born when dramatic positive therapeutic effects were observed. A preparation of a combination of Eco-Ultrafiltrates from the liver, pancreas, placenta, stomach, intestinal, mucosa (LPPSIM) was developed next, in order to assist in the regeneration of damaged gastro-intestinal systems and in the treatment of metabolic diseases (such as diabetes).
The impressive responses led to the design of various combinations of Eco-Ultrafiltrates of various organs and tissues for biological regeneration of disordered organ systems, as well as organ-specific formulas. (Other organ-specific Eco-Ultrafiltrates are available by request.)
Stem cell transplantation is based on several scientific principles, some of which are very important for an explanation of the therapeutic purpose of Eco-Ultrafiltrates.
Stem cell transplantation is an invasive, complicated, and expensive procedure that is only available for extreme cases. (Stem cell transplantation costs upwards of US$20,000.) Eco-Ultrafiltrates use similar principles and technology to make the benefits of stem cells available and affordable to everyone.

This means that corresponding cells of identical organs of different animal species (including humans) are biologically similar. For example, the hepatocyte, the main cell of livers, is almost the same in all vertebrates. We could make a similar statement about any of approximately 200 kinds of cells in the bodies of human beings and animals. Scientists call this the 'principle of organospecificity.'
There are no antigenic (anti-body generating) differences between corresponding cells of the identical organ of different animal and human species. This further supports the principle of 'organospecificity.'

The great majority of proteins from different organisms are similar over the entire amino acid sequence, i.e. they are homologous to each other, and, in general, carry out similar functions. Scientists call this the 'principle of homology.'
The same applies to all other types of molecules - in particular to those of low molecular weight that serve as the control mechanisms in all individual cells, as well as between the cells of various tissues and organs.
In order to 'fine-tune' the therapeutic benefits of stem cell transplantation, scientists developed Eco-Ultrafiltrates of many organs and tissues, utilizing animal fetuses to be used orally for milder cases and in-between stem cell transplantation treatments.
Using stem cell technology, Eco-Ultrafiltrates supply the biological building blocks for rejuvenation and regeneration on a molecular level.

The finished product is a cell-free, but very bioactive
and completely sterile and safe, liquid extract.
EUF (Eco-Ultrafiltrates) are organ-specific preparations composed of molecules of stem cells containing animal fetal cells that are nanometers in diameter.
Various organ and tissue-specific Eco-Ultrafiltrates (EUF) are manufactured to biologically balance and complement various body systems, such as the central nervous system, immune system, and gastro-intestinal system. Eco-Ultrafiltrates (EUF) offer a wide variety of products for specific organs, tissues and ailments, including extracts of placenta. The range of indications for the therapeutic use of Eco-Ultrafiltrates (EUF) comprises functional weakness due to chronic diseases, chronic degenerative diseases, degeneration and inefficiency due to aging, among others.
Since EUF (Eco-Ultrafiltrates) are so small and have such a low molecular weight of organic ingredients, it can be absorbed through intact mucosa, when taken orally.
Therapeutic efficacy lies in the content of Eco-Ultrafiltrates, which supply the ‘biological building blocks’ on the molecular level for cells. They serve primarily for substitution, and secondarily for triggering of repair and regeneration, for which the homologous (organ specific) molecules are necessary.
The decisive factor is the organo-specificity and system-specific preparations of Eco-Ultrafiltrates
composed of molecular structures that promote focused healing and revitalization.
The body’s response to the application of Eco-Ultrafiltrates generally takes 3 to 4 weeks from beginning use to observable function or structural improvement.
EUF (Eco-Ultrafiltrates) are organ-specific or system-specific preparations composed of molecules of stem cells and, therefore, can be effective against a wide variety of ailments.

EUF (Eco-Ultrafiltrates) are extracts from stem cells containing animal fetal tissues or organs of very low molecular weight (less than 10,000 Daltons). This incredibly small size represents approximately 1/9th of the diameter of the smallest known viruses. (The smallest virus yet observed under electron microscope is 27 nanometers in diameter.) During the manufacturing process, cells and other material of high molecular weight are separated from molecules of low molecular weight by multiple and thorough filtration methods using micro-filters. The final product is cell and protein-free, but very bioactive and contains molecular elements up to a nominal molecular weight of 10,000 Da (Daltons).
Eco-Ultrafiltrates are free of chemical additives. Undesirable side-effects of EUF are not known.
Eco-Ultrafiltrates are obtained from stem cells containing fetal organs or tissues of rabbits from a closed colony of rabbits,* as required by the United States’ FDA and the World Health Organization (WHO). No rabbits are killed during this process.
* From a Certified Closed Colony of 25 generations, since 1973, in accordance with guidelines of the WHO, FDA and the AAALAC (Association for Assessment of Accreditation of Laboratory Animal Care)
One therapeutic cycle consists of 20, 40 or 60 ampoules of Eco-Ultrafiltrates (EUF). The preparations are to be taken undiluted, between meals.
The content of an ampoule is not to be swallowed immediately, but, rather, swished around in the mouth for 10 to 30 seconds for maximum absorption.
Eco-Ultrafiltrates have a shelf-life of 6 years, if kept in refrigeration at the optimum temperature from +2°C to +10°C (not frozen) and fully protected from direct sunlight.
For more information on these other EUF (Eco-Ultrafiltrates), please Contact Us
Featured EUF Products |
| Oral Supplements |
| LPPSIM Liver-Pancreas-Placenta-Stomach-Intestinal-Mucosa |
| CNS (Brain) |
| Thymus |
The Full EUF Range of Products*Only Available in quantities of 5 boxes or more |
| Topical Cosmetic Application (applied directly to the skin) |
| Skin |
| Mesenchyme |
| Placenta Male / Female |
| Oral Supplements |
| Male Revitalization Comprises: Testis, Placenta, Adrenal Cortex, CNS (Brain); all from male rabbits |
| Female Revitalization Comprises: Ovary, Placenta, Adrenal Cortex, CNS (Brain); all from female rabbits |
| Immune Comprises : Thymus, Lymphnodes, Mesenchyme |
| Placenta - Male specific Placenta - Female specific |
| Lymphnodes (with 3% Transfer Factors) |
| Ovary |
| Testis |
| Lung-Stomach-Intestine |
| Heart (Cardio Myoblast) |
| Eye |
| Peripheral Muscle |
| Kidney |
| Liver |
| Adrenal Cortex - Male specific Adrenal Cortex - Female specific |
| Smooth Muscle |
| Stomach |
| Parasympathicus Of Autonomous NS |
| Adrenal Medulla |
| Prostate |
| Pituitary / Hypothalamus |
| Intestine |
| Colon |
| Pancreas |
| Bone |
| Cartilage / Synovia |
| Lungs |
| Skin |
| Gingiva |
| Bone Marrow |
| Blood |
| Spinal Cord |
| Mesenchyme |